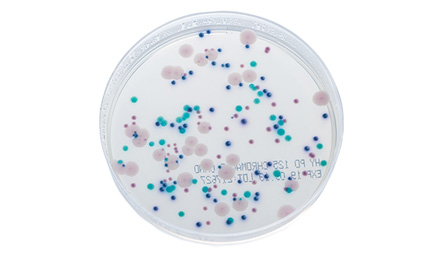

Product: CHROMagar Candida
CHROMagar Candida
Cat No. PD125
Isolation and differentiation of Candida spp. by specific enzymatic chromogenic reactions
CHROMagar Candida
Cat No. PD125
Isolation and differentiation of Candida spp. by specific enzymatic chromogenic reactions